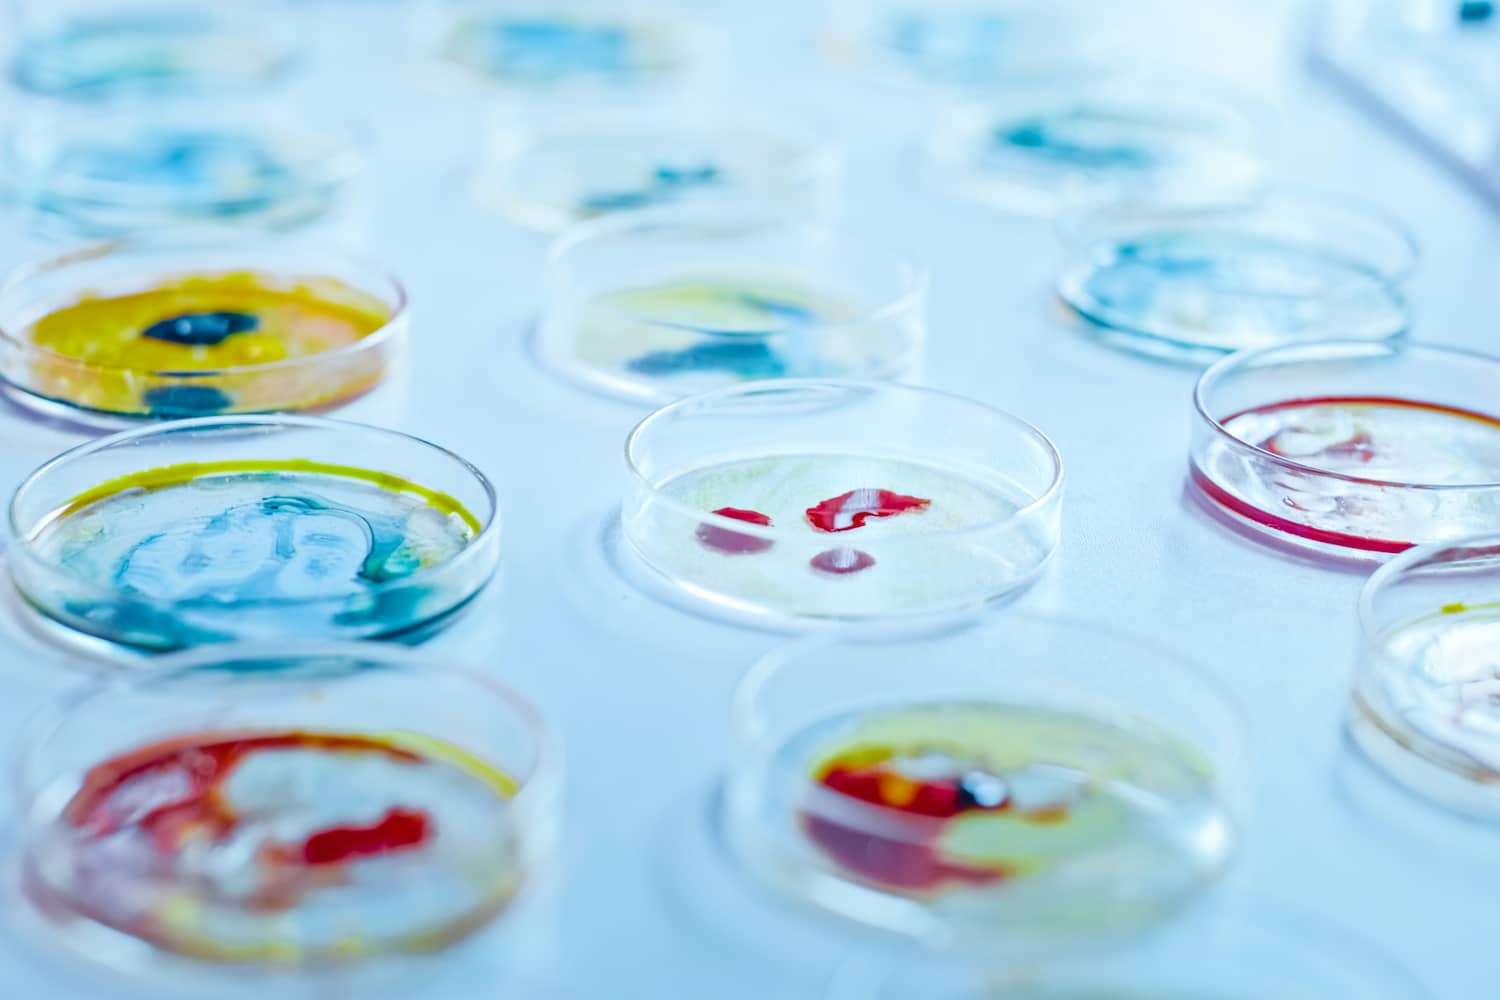
Mikrobiológiai vizsgálat

Hormonvizsgálat
Számtalan testi tünet hátterében valamilyen hormonzavar áll. Aki arra gyanakszik, hogy ilyen jellegű problémája lehet, mindenképpen megbízható orvosi segítségre szorul. A kivizsgálás minden esetben laborteszteket is jelent.
A hormonzavarok hátterében leggyakrabban a pajzsmirigy, a mellékvese és a nemi hormonok szintjének változása áll.
Az egyik legfontosabb hormontermelő szervünk a pajzsmirigy. Működését az agyalapi mirigyben termelődő pajzsmirigy–serkentő hormon (TSH) szabályozza. Ennek hatására nő a bélből történő jódfelvétel és a vérben keringő pajzsmirigyhormonok, az L-tiroxin (T4) és az L-trijódtironin (T3) mennyisége. Laboratóriumunkban vérmintából mutatjuk ki ezeket a hormonokat, és szükség esetén orvosaink gyógyszeres kezelést vagy műtétet javasolnak a panaszok megszüntetésére.
A mellékvesekéreg számos hormont termel, ezek közül a legfontosabbak a szervezet vízháztartását szabályozó aldoszteron és a szénhidrát raktározást felügyelő kortizol. Mindkettő termelődését az agyalpi mirigy ACTH nevű fehérjéje szabályozza. A fent említett hormonok vértesztekből közvetlenül és fájdalommentesen kimutathatók. Laboratóriumunkban lehetőség nyílik továbbá a dexamethason szupressziós teszt elvégzésére is, melynek lényege, hogy dexamethason hatására változik az ACTH termelődés és ennek köszönhetően a mellékvesekéreg működése is. A szer beadását követően vérmintája kortizol tartalmának mérésével megtudhatjuk, hogy szervezete az egészségesnek megfelelően reagál-e.
Laboratóriumunkban lehetőség van a nemi hormonok, nőknél az ösztrogén és a progeszteron, férfiak esetében a tesztoszteron szintjének mérésére is.